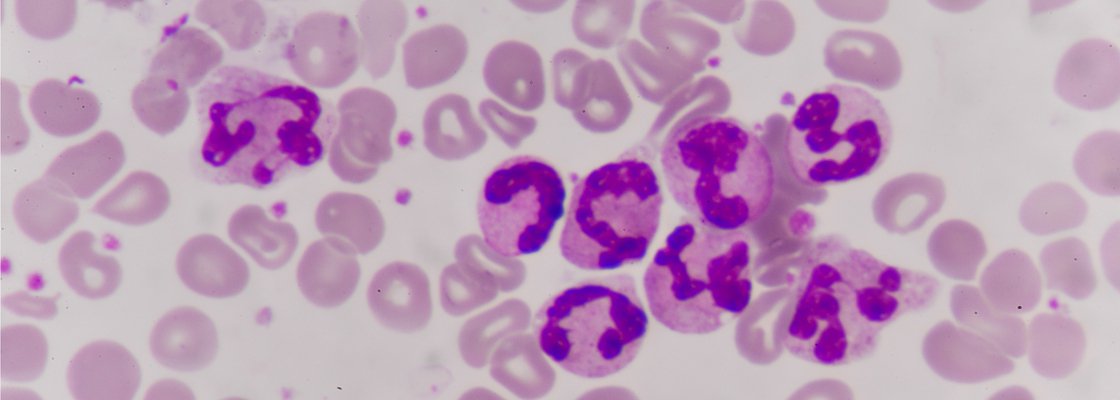
Cancer Event

America’s Longest War, Against Cancer
- In-Person
- New America
740 15th St NW #900
Washington, D.C. 20005 - 12PM – 1:45PM EDT
In 1971, Richard Nixon declared war on cancer. Five decades and billions of dollars later, cancer remains the second leading cause of death in the United States. But promising advances in immunotherapy and other cutting-edge research, plus efforts like Joe Biden’s “cancer moonshot,” have reinvigorated the battle and raised new hopes. Now the entire way we look at cancer is changing from monolithic condition to a wide range of different diseases requiring different approaches.
Throughout the ‘80s and ‘90s, fighting cancer meant using targeted therapies to attempt to wipe out compromised cells. But today iconoclastic cancer researchers are taking a different approach: What if, they ask, the human body is more like an ecosystem? What if cancer cells are active members within that habitat? Billions of years of evolution have endowed ecosystems with ways of remaining healthy despite predators, exploiters, cheaters, and deadbeats. And if researchers apply predictable ecological management principles to cancer treatment we might reframe the disease in a way that leads to effective new treatments instead of an ever unattainable cure.
Join Future Tense in Washington, D.C., as we gather the experts who are reassessing how we understand, prevent, and treat cancer.
Future Tense is a partnership of Slate , New America , and Arizona State University.
Follow the conversation online using #FTCancer and following @FutureTenseNow.
Lunch will be served.
Agenda:
12:00 – 12:10 pm: The Ecology of Cancer
Athena Aktipis
Assistant Professor, Psychology Department, Arizona State University
Co-Founder, International Society for Evolution, Ecology and Cancer
@AthenaAktipis
12:10 – 12:40 pm: Learning from the Ailments of Our Ancestors
Kate Hunt
Bioarchaeologist, 106 Group
Moderator:
Kathryn Bowers
Co-author, Zoobiquity: The Astonishing Connection Between Human and Animal Health
Future Tense Fellow, New America
@KathrynSBowers
12:40 – 12:55 pm: Notes on a Small Thing
Jacob Brogan
Journalist and critic
@Jacob_Brogan
12:55 – 1:45 pm: Changing The Way We Think About Beating Cancer
Athena Aktipis
Assistant Professor, Psychology Department, Arizona State University
Co-Founder, International Society for Evolution, Ecology and Cancer
@AthenaAktipis
Donna Marie Manasseh, M.D.
Director of Breast Surgery, Maimonides Breast Cancer Center
David Reese, M.D.
Senior Vice President of Translational Sciences and Discovery Research (Interim), Amgen
Joshua Schiffman, M.D.
Professor, Department of Pediatrics, University of Utah
Investigator, Huntsman Cancer Institute
Moderator:
William Saletan
National correspondent, Slate
@saletan